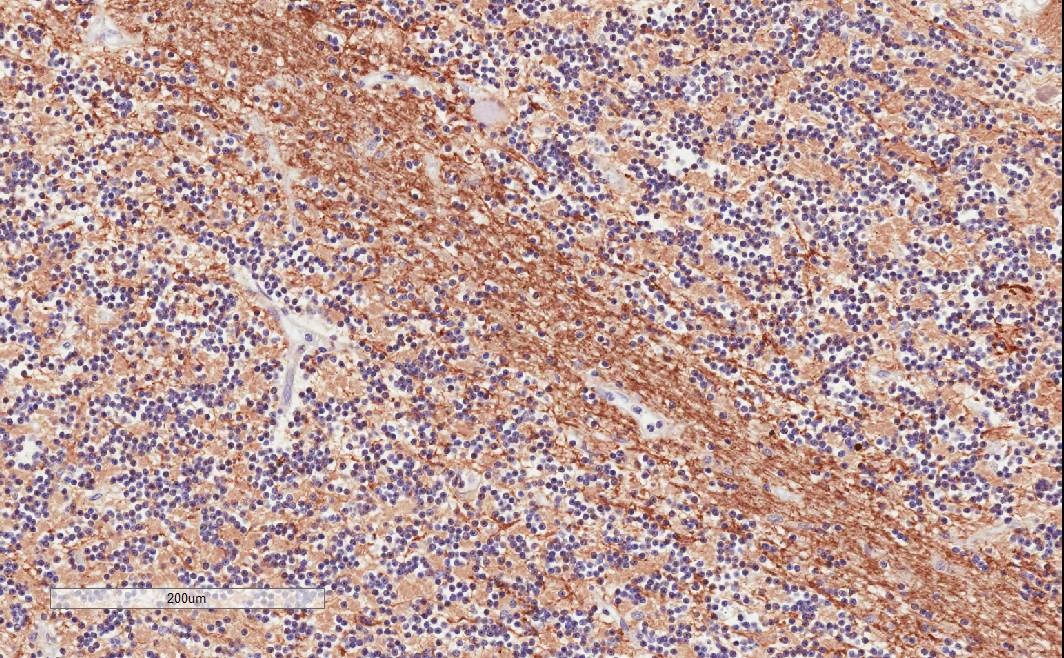

Formulation Supplied at 0.5 mg/ml in Tris saline, 0.02% sodium azide, pH7.3 with 0.5% bovine serum albumin.
| |
Unit Size 100 µg | |
Storage Instructions Aliquot and store at -20°C. Minimize freezing and thawing. | |
Synonym / Alias Names TPPP|tubulin polymerization-promoting protein|tubulin polymerization promoting protein|TPPP1|TPPP/p25|p25alpha|p25|p24|glycogen synthase kinase 3 (GSK3) inhibitor p24|brain specific protein p25 alpha | |
Usage Summary Additional validation: This antibody has been successfully used in the following paper: Sikorski et al. (2018) PMID: 30377371. | |
Accession ID NP_008961.1 | |
Blocking Peptide EBP09800 | |
Immunogen Peptide with sequence C-DPSKDRAAKRLSLES, from the internal region of the protein sequence according to NP_008961.1. | |
Peptide Sequence C-DPSKDRAAKRLSLES | |
Purification Method Purified from goat serum by ammonium sulphate precipitation followed by antigen affinity chromatography using the immunizing peptide. | |
Shipping Instructions Refrigerated | |
Predicted Species Human | |
Reactive Species Human, Mouse, Rat | |
Human Gene ID 11076 | |
Mouse Gene ID 72948 | |
Rat Gene ID 361466 | |
Product Grade ![]() | |
IHC Results In paraffin embedded Human Cerebellum shows strong staining of axonal bundles through the granular layer. Recommended concentration: 1-2µg/ml. Paraffin embedded Human Cortex. Recommended concentration: 3.75µg/ml. | |
ELISA Detection Limit Antibody detection limit dilution 1:32000. | |
Western Blot Approx 26kDa band observed in Human Brain (Cerebellum), Mouse and Rat Brain lysates (calculated MW of 23.7kDa according to NP_008961.1). The observed molecular weight corresponds to earlier findings in literature with different antibodies (Acevedo et al, Exp Cell Res. 2007 Dec 10;313(20):4091-106; PMID: 18028908). Recommended concentration: 0.001-0.01µg/ml. Primary incubation was 1 hour. An additional band of unknown identity was also consistently observed at 17kDa. This band was successfully blocked by incubation with the immunizing peptide. | |
Application Type Pep-ELISA, WB, IHC |
Goat Anti-TPPP/p25 Antibody
$423.00
| SKU | Unit Size | Price |
|---|---|---|
Select a unit size:
Selected References [{"pmid": 30377371, "intro": "This antibody has been successfully used in the following paper:", "title": "A high-throughput pipeline for validation of antibodies", "author": "Krzysztof Sikorski, Adi Mehta, Marit Inngjerdingen, Flourina Thakor, Simon Kling, Tomas Kalina, Tuula A. Nyman, Maria Ekman Stensland, Wei Zhou, Gustavo A. De Souza, Lars Holden, Jan Stuchly, Markus Templin and Fridtjof Lund-Johansen", "journal": "Nat Methods. 2018 Nov;15(11):909-912"}] |
Documents |